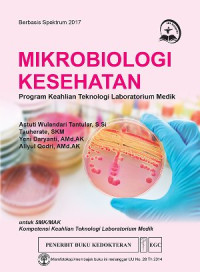
Image of Mikrobiologi kesehatan : Program keahlian teknologi Laboratorium Medik

Detail Cantuman
Advanced Search
BUKU TEXT KOLEKSI PERPUS
Mikrobiologi kesehatan : Program keahlian teknologi Laboratorium Medik
Buku ini disusun berbasis Spektrum 2017 untuk memenuhi kebutuhan belajar mengajar siswa SMK Kompetensi Keahlian Teknologi Laboratorium Medik.
Materi dalam buku ini tersusun secara sistematis dan dilengkapi ilustrasi serta latihan soal sehingga memudahkan peserta didik untuk memahami materi dan belajar mandiri.
Daftar Isi
Pengenalan Mikrobiologi
Bakteriologi
Protozoa
Helmintologi
Mikologi
Teknik Aseptik
Ketersediaan
B002234Q1 | 616.9041 TAN m | RAK KOLEKSI BUKU (4-C.5) | Tersedia |
Informasi Detil
Judul Seri |
-
|
---|---|
No. Panggil |
616.9041 TAN m
|
Penerbit | EGC : Jakarta., 2017 |
Deskripsi Fisik |
-
|
Bahasa |
Indonesia
|
ISBN/ISSN |
978-979-044-810-0
|
Klasifikasi |
616.9041 TAN m
|
Tipe Isi |
-
|
Tipe Media |
-
|
---|---|
Tipe Pembawa |
-
|
Edisi |
-
|
Subyek | |
Info Detil Spesifik |
-
|
Pernyataan Tanggungjawab |
-
|
Versi lain/terkait
Tidak tersedia versi lain